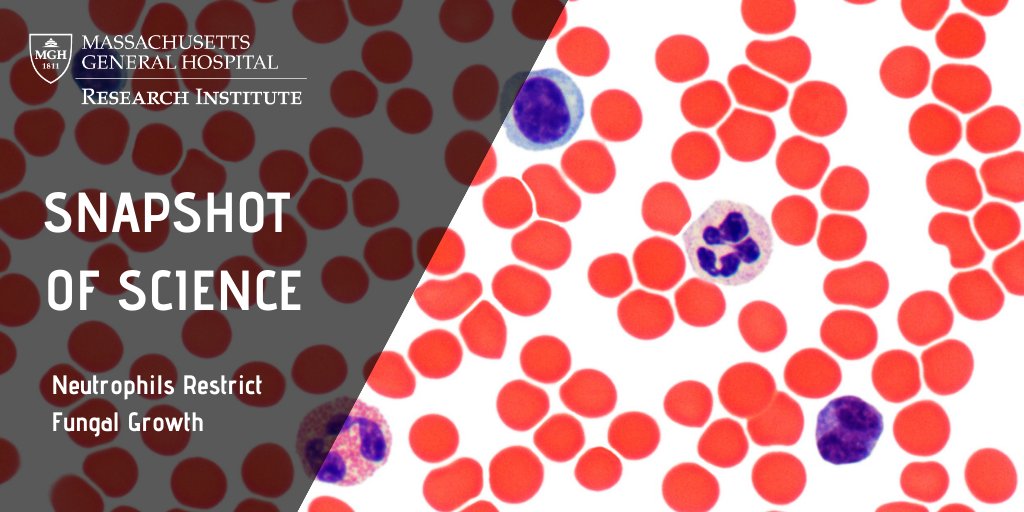
Mass General Brigham Research tweet media

CEMS at MGH
46 posts


@CEMatMGH
Official Twitter feed of the Center for Engineering in Medicine and Surgery (CEMS) at the Massachusetts General Hospital and the Harvard Medical School.





In a recent @BioactiveMat publication, researchers from @MGHSurgery developed a hydrogel that allows for quick burn dressing changes while minimizing pain. Read more: massgeneral.org/news/press-rel… @ustaosma @AyseAsatekin @AslihanGokaltun @MassGeneralNews @CEMatMGH


Researchers from the @CEMatMGH and the @UMNIEM recently established an #engineering research center, called Advanced Technologies for Preservation of Biological Systems (ATP-Bio), that will develop new technologies for biopreservation. @MassGeneralNews mgriblog.org/2020/10/22/bio…

We are seeking postdoctoral fellows in multiple areas (Tissue Engineering, Biopreservation, and others) at the Center for Engineering in Medicine and Surgery (CEMS) @CEMatMGH at the Mass. General Hospital and Harvard Medical School.

SARS-CoV-2 seems to elicit highly specific neutralizing antibodies. biorxiv.org/content/10.110…


Happy International Day of Women and Girls in #Science! In honor of #WomenInScienceDay, check out our recent post about @WiS_MGHMartinos and the great work they are doing to support #WomenInScience. @MGHMartinos mghresearchinstitute.org/2019/12/12/a-q…